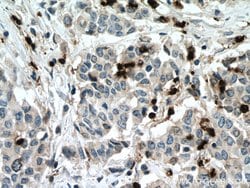

Promotional price valid on web orders only. Your contract pricing may differ. Interested in signing up for a dedicated account number?
Learn More
Learn More
MPO Rabbit anti-Human, Polyclonal, Proteintech


Rabbit Polyclonal Antibody
Supplier: Proteintech Group Inc 222251AP150UL

Description
This antibody is specific to MPO.
Myeloperoxidase (MPO) is a hemoprotein that is abundantly expressed in neutrophils and secreted during their activation. Native Myeloperoxidase is represented as a covalently bound tetrameric complex of two glycosylated alpha chains with a molecular weight range of 59 - 64 kDa, and two unglycosylated beta chains (MW approximately 14 kDa) with total MW approximately 150 kDa and a theoretical pI of 9.2. Traditionally, myeloperoxidase was considered as a main target of anti-neutrophil cytoplasm antibodies (ANCA), the serological markers for certain systemic vasculities such as periarteriitis nodosa, microscopic polyarteriitis and pulmonary eosinophilic granulomatosis (Churg-Strauss syndrome). Low to moderate anti-myeloperoxidase autoantibody levels are also reported in rheumatoid arthritis. Recently, it was shown that myeloperoxidase participates in the initiation and progression of cardiovascular disease. Myeloperoxidase possesses potent proinflammatory properties and may contribute directly to tissue injury. Now Myeloperoxidase is under consideration as one of the most promising cardiac markers. Myeloperoxidase is part of the host defense system of polymorphonuclear leukocytes and myeloperoxidase is responsible for microbicidal activity against a wide range of organisms. In the stimulated PMN (polymorphonuclear leukocytes), MPO catalyzes the production of hypohalous acids, primarily hypochlorous acid in physiologic situations, and other toxic intermediates that greatly enhance PMN microbicidal activity.Specifications
| MPO | |
| Polyclonal | |
| Unconjugated | |
| MPO | |
| MPO, myeloperoxidase | |
| Rabbit | |
| Antigen Affinity Chromatography | |
| RUO | |
| 4353 | |
| -20°C | |
| Liquid |
| Immunohistochemistry (Paraffin), Immunoprecipitation, Western Blot | |
| 0.51 mg/mL | |
| PBS with 50% glycerol and 0.02% sodium azide; pH 7.3 | |
| P05164 | |
| MPO | |
| MPO Fusion Protein Ag17564 | |
| 150 μL | |
| Primary | |
| Human | |
| Antibody | |
| IgG |
Product Content Correction
The Fisher Scientific Encompass Program offers items which are not part of our distribution portfolio. These products typically do not have pictures or detailed descriptions. However, we are committed to improving your shopping experience. Please use the form below to provide feedback related to the content on this product.
Product Title
Spot an opportunity for improvement?Share a Content Correction